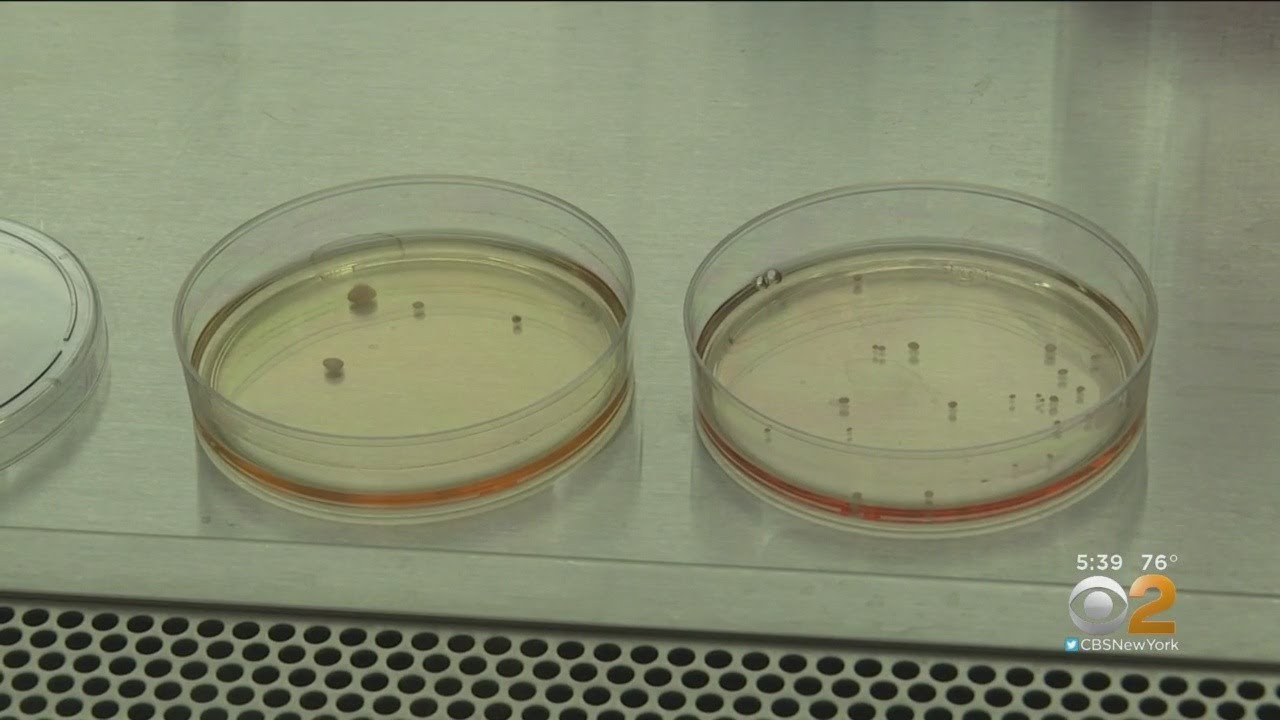
cbs new york weather Creating Replica Brains May Help Find Treatment For Tumors

CBS2's Dr. Max Gomez has the latest on scientists growing miniature brains to help with brain tumor research.
CBS2's Dr. Max Gomez has the latest on scientists growing miniature brains to help with brain tumor research.cbs new york weather Creating Replica Brains May Help Find Treatment For Tumors | |
| 5 Likes | 5 Dislikes |
| 105 views views | followers |
| News & Politics | Upload TimePublished on 10 Sep 2019 |
Related keywords
kristine johnson facebook,maurice dubois illness,kristine johnson husband,cbs 2 news at 5,cbs new york tv schedule,cbs local 2,cbs new york twitter,local tv on firestick,dr max gomez waterbury ct,kristine johnson health,cbs 2 news at 5pm new york,cbs new york logo,dr max gomez watertown ct,cbs local los angeles,local tv channels app,cbs new york app,local tv brands,cbs new york radio,dr. max gomez age,cbs new york weather team,local tv streaming,local tv stations near me,local tv on roku,kristine johnson surgery,local tv app for android,dr max gomez diabetes,kristine johnson net worth,cbs new york phone number,cbs new york office,cbs new york local,local tv box,dr max gomez family,kristine johnson the talk,cbs new york channel,local tv repair,dr max gomez cbs,maurice dubois mero,cbs 2 news at 5 anchors,kristine johnson height,local tv channels philippines,cbs 2 news at 5 los angeles,cbs local philly,dr max gomez wife,cbs new york times,cbs local weather,cbs local schedule,local tv brand philippines,maurice dubois bell's palsy,cbs new york live,contact dr max gomez,kristine johnson attorney,cbs new york sports,maurice dubois cbs evening news,kristine johnson bio,kristine johnson anchor,maurice dubois family,cbs local channel,cbs local chicago,is dr max gomez married,cbs local news nyc,cbs local miami,kristine johnson age,kristine johnson plastic surgery,cbs local sacramento,cbs new york reporters,cbs local news live,dr max gomez trochez,cbs local news dallas,cbs new york school closings,cbs local app,cbs new york contact,kristine johnson salary,local tv app,dr max gomez wikipedia,cbs local denver,maurice dubois net worth,cbs new york furry friends,cbs new york schedule,local tv stations,maurice dubois salary,cbs new york live stream,cbs local news weather,wcbs-tv cbs 2 news at 5,local tv patrol,cbs new york,kristine johnson news anchor,cbs new york traffic,cbs new york facebook,cbs local pittsburgh,kristine johnson twitter,cbs local news,local tv antenna,dr max gomez biography,dr max gomez ct,maurice dubois house,dr max gomez cbs news,kristine johnson md,cbs new york address,maurice dubois instagram,maurice dubois height,cbs local stations,local tv news,dr max gomez twitter,kristine johnson nationality,maurice dubois annual salary,cbs new york studio,cbs new york city,local tv channels,cbs local baltimore,when was dr max gomez born,dr max gomez education,cbs2 news at 5pm,cbsnewyork youtube,maurice dubois sons,local tv app philippines,cbs local boston,kristine johnson actress,dr max gomez surgery,cbs new york jobs,cbsnewyork/the dig,dr. max gomez birthday,local tv streaming philippines,maurice dubois the kid mero,cbs2 news at 5 chicago,maurice dubois parents,maurice dubois age,maurice dubois obituary,maurice dubois wife,maurice dubois nationality,dr max gomez net worth,kristine johnson wcbs,local tv shows in philippines,cbs new york directv,maurice dubois desus and mero,kristine johnson instagram,cbs2 news at 5 cast,maurice dubois bronx,
Không có nhận xét nào:
Đăng nhận xét